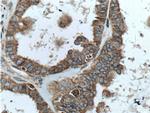
TRAPA/SSR1 Antibody in Immunohistochemistry (Paraffin) (IHC (P))

Search
Proteintech
TRAPA/SSR1 Polyclonal Antibody
{{$productOrderCtrl.translations['antibody.pdp.commerceCard.promotion.promotions']}}
{{$productOrderCtrl.translations['antibody.pdp.commerceCard.promotion.viewpromo']}}
{{$productOrderCtrl.translations['antibody.pdp.commerceCard.promotion.promocode']}}: {{promo.promoCode}} {{promo.promoTitle}} {{promo.promoDescription}}. {{$productOrderCtrl.translations['antibody.pdp.commerceCard.promotion.learnmore']}}
产品信息
10583-1-AP
种属反应
已发表种属
宿主/亚型
分类
类型
抗原
偶联物
形式
浓度
规格
纯化类型
保存液
内含物
保存条件
运输条件
产品详细信息
Immunogen sequence: MRLLPRLLL LLLLVFPATV LFRGGPRGLL AVAQDLTEDE ETVEDSIIED EDDEAEVEED EPTDLVEDKE EEDVSGEPEA SPSADTTILF VKGEDFPANN IVKFLVGFTN KGTEDFIVES LDASFRYPQD YQFYIQNFTA LPLNTVVPPQ RQATFEYSFI PAEPMGGRPF GLVINLNYKD LNGNVFQDAV FNQTVTVIER EDGLDGETIF MYMFLAGLGL LVIVGLHQLL ESRKRKRPIQ KVEMGTSSQN DVDMSWIPQE TLNQINKASP RRLPRKRAQK RSVGSDE (1-286 aa encoded by BC007710)
靶标信息
The signal sequence receptor (SSR) is a glycosylated endoplasmic reticulum (ER) membrane receptor associated with protein translocation across the ER membrane. The SSR consists of 2 subunits, a 34-kD glycoprotein encoded by this gene and a 22-kD glycoprotein. This gene generates several mRNA species as a result of complex alternative polyadenylation. This gene is unusual in that it utilizes arrays of polyA signal sequences that are exclusively non-canonical.
仅用于科研。不用于诊断过程。未经明确授权不得转售。
生物信息学
蛋白别名: DKFZp781N23103; Signal sequence receptor subunit alpha; signal sequence receptor, alpha; SSR alpha subunit; SSR-alpha; SSR1; translocon-associated protein alpha; translocon-associated protein alpha subunit; Translocon-associated protein subunit alpha; TRAP alpha; TRAP-alpha; unnamed protein product
基因别名: 2510001K09Rik; 6330400D04; AI159733; AI452176; PSEC0262; SSR; SSR1; TRAPA
UniProt ID: (Human) P43307, (Mouse) Q9CY50
Entrez Gene ID: (Human) 6745, (Mouse) 107513